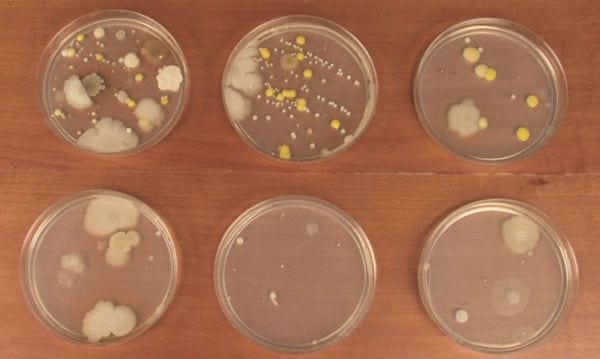
4th Grade Science Experiments Petri Steve Spangler 6 petri dishes growing a variety of molds and bacteria

Nothing gets kids more excited for science than hands-on experiments! Watch your 4th grade science students’ eyes light up when they try some of these activities. You’ll find physics, biology, engineering, chemistry, and more. These projects are easy to set up and really help drive the learning home. Get ready for some science fun!
To help you find the right 4th grade science projects and activities, we’ve rated them all based on difficulty and materials:
Difficulty:
- Easy: Low or no-prep experiments you can do pretty much any time
- Medium: These take a little more setup or a longer time to complete
- Advanced: Experiments like these take a fairly big commitment of time or effort
Materials:
- Basic: Simple items you probably already have around the house
- Medium: Items that you might not already have but are easy to get your hands on
- Advanced: These require specialized or more expensive supplies to complete
Jump to:
- 4th Grade Science Fair Projects
- 4th Grade STEM Challenge Science Projects
- 4th Grade Motion and Energy Science Activities
- More 4th Grade Science Projects and Experiments
4th Grade Science Fair Projects
These 4th grade experiments also work well as science fair projects. Try changing up the variables to turn it into a real experiment, then form a hypothesis and find out what happens.
Blow unpoppable bubbles

Difficulty: Easy / Materials: Medium
A soap bubble you can hold in your hand? It’s true! A little glycerin makes the soap bubble layers stronger, so you can even toss them gently from person to person.
Learn more: Unpoppable Bubbles Experiment at Learning Resources
Grow crystal names

Difficulty: Easy / Materials: Medium
No list of 4th grade science projects would be complete without crystals! Kids of all ages love growing crystals, making this an ideal way to learn about supersaturated solutions. The classic experiment gets a new twist when you have kids shape pipe cleaners into their own names first.
Learn more: Crystal Letters at Playdough to Plato
Grow bacteria in petri dishes
Difficulty: Medium / Materials: Medium
Your students will truly feel like scientists when they perform this classic experiment. They’ll prep the dishes with agar, swab different surfaces, and see what bacteria they grow. It’s gross science, but it’s also easy and impressive.
Learn more: Growing Bacteria at Steve Spangler Science
See coastal erosion in action

Difficulty: Easy / Materials: Medium
Here’s a cool experiment to include in your unit on oceans. Build a miniature coastline, then see how wave action erodes the shore.
Learn more: Erosion Experiment at Little Bins for Little Hands
Erupt a lemon volcano

Difficulty: Easy / Materials: Basic
Early chemistry experiments with acids and bases are always a lot of fun. This one uses the natural acids of lemon juice and adds a little food coloring to up the wow factor.
Learn more: Lemon Volcano at STEAM Powered Family
Sink and float to explore density

Difficulty: Easy / Materials: Basic
Adding items like salt or sugar to water changes its density, as does the temperature itself. Turn this into a 4th grade science fair project by experimenting with different solutions and forming hypotheses about the results.
Learn more: Salt Water Density at Science Kiddo
Discover a density rainbow
Difficulty: Medium / Materials: Basic
Colorful, simple, and impressive: It’s the trifecta of 4th grade science experiments! Wow your students by layering colored sugar water as you learn about density, adhesion, and cohesion.
Transform milk into plastic
Difficulty: Medium / Materials: Basic
Plastic seems incredibly modern, but people have been making casein plastic from milk for centuries. In this 4th grade science project, students experiment to create the formula for the best milk plastic. They’ll be amazed at the results!
Simulate an earthquake

Difficulty: Medium / Materials: Basic
The ground under our feet may feel solid, but an earthquake changes that pretty quickly. Use Jell-O to simulate the Earth’s crust, then see if you can build an earthquake-proof structure for a practical and fascinating 4th grade science fair project.
Learn more: Earthquake Simulation at Teaching Science
Test Sharpie solubility

Difficulty: Easy / Materials: Medium
Find out if Sharpie markers are really permanent with this 4th grade science project that uses the scientific method to explore solutes and solvents.
Learn more: Sharpie Solubility at Around the Kampfire
Find out if mood rings really work

Difficulty: Easy / Materials: Medium
Apply the rigors of the scientific method to mood rings! Find out what makes mood rings change color, then see if they really reflect a person’s mood.
Learn more: Mood Rings Validity Test at Education.com
Create a new plant or animal

Difficulty: Easy / Materials: Basic
Kids will really get into this project, indulging their creativity as they invent a plant or animal that’s never been seen before. They’ll need to be able to explain the biology behind it all, though, making this an in-depth project you can tailor to any class.
Learn more: Create an Organism at I Love 2 Teach
Investigate decomposition

Difficulty: Easy / Materials: Easy
Yup, it’s gross … so kids will love it! Seal food items in a plastic bag and experiment to see what factors affect their decomposition, helped along by a heaping dose of mold.
Learn more: Decomposition at Mystery Science
Assemble a lung model
Difficulty: Medium / Materials: Medium
With just a few supplies including balloons and a plastic bottle, you can make an impressive working model of human lungs. This makes a very cool 4th grade science fair project.
Explore the causes of tooth decay
Difficulty: Easy / Materials: Medium
They hear it from their parents all the time, but this experiment will prove to your students once and for all what can happen to their teeth when exposed to different drinks such as soda and milk. This is one of those classic 4th grade science fair projects every kid should try.
4th Grade STEM Challenge Science Projects
For students who love to tinker, STEM challenges can spark incredible 4th grade science fair projects. Here are some of our favorites for this age group.
Engineer a drinking-straw roller coaster

Difficulty: Easy / Materials: Basic
STEM challenges are always a hit with kids. We love this one, which only requires basic supplies like drinking straws. (Get more 4th grade STEM challenges here.)
Learn more: Drinking Straw Roller Coaster at Frugal Fun for Boys and Girls
Make a wigglebot

Difficulty: Medium / Materials: Medium
Who knew electricity could be so adorable? Explore the science behind batteries and motors by creating a simple “wigglebot.” Experiment with weights to throw the motor off balance and create fun designs.
Learn more: Wigglebot at Research Parent
Construct a working flashlight

Difficulty: Easy / Materials: Medium
You’ll only need a few supplies to guide your students in building their own LED flashlights. They’ll learn how electricity travels and the way circuits work. The slideshow available through the link makes this lesson a breeze for teachers too.
Learn more: DIY Flashlight at Mystery Science
Build a hovercraft

Difficulty: Easy / Materials: Medium
It’s not exactly the same model the military uses, but this simple hovercraft is a lot easier to build. An old CD and a balloon help demonstrate air pressure and friction in this fun 4th grade science experiment.
Learn more: DIY Hovercraft at Education.com
Create a smartphone projector

Difficulty: Medium / Materials: Medium
No projector in your classroom yet? No problem! Have your students help you construct one for your smartphone using a cardboard box and large magnifying glass. They’ll learn about convex lenses and how the brain processes images too.
Learn more: DIY Smartphone Projector at The STEM Laboratory
Set up a pulley system

Difficulty: Medium / Materials: Medium
The science of machines never fails to fascinate kids. In this experiment, they’ll design their own pulley system to make it easier to lift an object.
Learn more: DIY Pulley at 123 Homeschool 4 Me
Design a working elevator
Difficulty: Medium / Materials: Basic
Engineering activities make for amazing hands-on learning. Challenge your 4th grade students to build an elevator that can safely lift a certain amount of weight.
Make a model seismometer

Difficulty: Medium / Materials: Basic
Explore the science of seismology and learn how scientists study earthquakes and their effects. This model seismometer is easy to build and fun to experiment with.
Learn more: Model Seismometer at Science Sparks
Conduct an egg drop

Difficulty: Medium / Materials: Basic
Here’s one more classic to add to our list of 4th grade science experiments: the egg drop! The great thing about this project is that kids can do it at any age, with different materials and heights to mix it up. Hit the link below to get an egg drop project designed just for 4th graders.
Learn more: Egg Drop at Buggy and Buddy
Demonstrate Newton’s laws of motion with balloon rockets
Difficulty: Medium / Materials: Medium
Who doesn’t love balloon rockets?! Your students will have a blast(off) displaying Newton’s third law of motion while learning about physics.
4th Grade Motion and Energy Science Activities
Many 4th grade science standards include units on energy and motion. These energy science activities offer cool hands-on ways to spice up your classroom lessons.
Flick marbles to learn transfer of energy

Difficulty: Easy / Materials: Basic
This experiment is a bit of a thinker: What will happen when one moving marble hits several stationary marbles sitting in a row? Flick the first marble and find out!
Learn more: Marble Energy Transfer at Frugal Fun for Boys and Girls
See energy transfer in action with sports balls
Difficulty: Easy / Materials: Basic
Place a tennis ball on top of a basketball and bounce them together to see how energy transfers from one object to another. This one is very easy, and kids will love seeing how high they can get the balls to bounce!
Go an on energy scavenger hunt

Difficulty: Easy / Materials: Basic
Emphasize the fact that energy is all around us in one form or another with this easy, free printable energy science activity. For a more advanced version, help students identify each kind of energy (kinetic, stored, heat, etc.) they find.
Learn more: Energy Scavenger Hunt at The Science Penguin
See a heat-powered windmill demonstrate convection
Difficulty: Medium / Materials: Basic
Heat rises, and its interaction with cooler air creates convection currents. Find out how we can put convection to work for us with this 4th grade science craft project.
Capture waves in a bottle

Difficulty: Easy / Materials: Basic
Here’s a quick and easy way to show wave action in a no-mess way. You don’t need to add a little ship to the bottle, but it does make it more fun!
Learn more: Waves in a Bottle at What I Have Learned Teaching
Assemble a wave machine
Difficulty: Medium / Materials: Medium
Turn this one into a class cooperative activity, or try it as a science fair project idea. Either way, it’s an incredibly fascinating way to demonstrate the energy science of waves.
Use a Slinky to demonstrate types of waves
Difficulty: Easy / Materials: Medium
A Slinky is more than just a toy—it’s also a terrific science manipulative! Use it to see waves in motion, both longitudinal and transverse.
Watch gravity beads prove Newton’s laws

Difficulty: Easy / Materials: Medium
You’ll need a loooooooong string of beads for this experiment. Make your own by taping dollar-store strings together, or buy a long bead garland. Pile them in a cup and get the beads going; it’s fascinating to watch inertia and gravity at work.
Learn more: Gravity Beads at Teach Beside Me
Spin marble tops to learn about inertia

Difficulty: Easy / Materials: Medium
Glue together marbles in a variety of pyramidal patterns to form tops, then form hypotheses about which will spin best. Afterwards, kids will have fun new toys to play with!
Learn more: Marble Tops at KidsActivities.com
Visualize the second law of motion with soda cans
Difficulty: Easy / Materials: Medium
Newton’s second law, concerning acceleration, force, and mass, can be a little hard to understand. This easy 4th grade science demo makes it a little easier to visualize.
More 4th Grade Science Projects and Activities
Use these cool science experiments to encourage a love of science, at home or in the classroom!
Measure a magnet’s attraction force

Difficulty: Easy / Materials: Basic
Fourth grade science students already know that magnets attract metal objects. In this experiment, they’ll measure to see how close a magnet needs to be to an object for the attraction to work. Mix things up with different sizes of magnets and objects of various weights.
Learn more: Magnet Measurements at Ashleigh’s Education Journey
See light refraction in action

Difficulty: Easy / Materials: Basic
This seems more like a magic trick, but we promise it’s science! Make colors seem to appear and disappear, change numbers into letters, and more.
Learn more: Light Refraction at Ronyes Tech
“Draw” on water with dry-erase marker
Difficulty: Easy / Materials: Basic
This is another one of those mind-blowing science demos that kids will want to try over and over again. Draw on a shallow bowl or plate with dry-erase markers, then slowly add water. The marker (which is insoluble in water) will float to the top!
Paint with sunscreen

Difficulty: Easy / Materials: Basic
Prove that sunscreen really does provide protection from harmful UV rays. Turn this into a full-blown experiment by trying different SPFs or comparing it to other creams or lotions without SPF.
Learn more: Paint With Sunscreen at Team Cartwright
Become human sundials

Difficulty: Medium / Materials: Basic
Choose a sunny day and grab some sidewalk chalk—your students are about to become sundials! They’ll practice measuring skills and learn about the movement of the sun across the sky.
Learn more: Human Sundial at Rhythms of Play
Mine for chocolate chips

Difficulty: Easy / Materials: Medium
If you’re learning about mineral resources, this quick hands-on activity is an interesting way to explore the effects of mining. Kids have two minutes to find as many chocolate chips as they can in a cookie. Will they smash it up and destroy it entirely? Pick them out one by one? This experiment can lead to intriguing discussions.
Learn more: Mining for Chocolate Chips at Sarah’s STEM Stuff
Assemble an edible DNA model

Difficulty: Easy / Materials: Medium
Use licorice sticks, four different-colored candies or fruits, and toothpicks to build an edible strand of DNA. Learn about chemical bonds and the helix shape, then eat your creation!
Learn more: Edible DNA Model at wikiHow
Layer an edible soil model

Difficulty: Easy / Materials: Medium
Digging in the dirt is fun, but it’s even more fun when you can eat the dirt when you’re finished! Create edible soil-layer models, complete with gummy worms, for a simple earth science project. (Find more edible science projects here.)
Learn more: Edible Soil Layers at Super Teacher Blog
Turn a penny green

Difficulty: Easy / Materials: Basic
Experiment with simple chemical reactions as you turn pennies green using vinegar. (Don’t forget to tell students that the Statue of Liberty is green for this very same reason!)
Learn more: Penny Reactions at Buggy and Buddy
Use marshmallows to explore Boyle’s law

Difficulty: Easy / Materials: Medium
Seeing Boyle’s law (which relates pressure and volume of gasses) in action makes it a little easier to understand and remember. This simple 4th grade science experiment uses marshmallows to make a great visual.
Learn more: Boyle’s Law at Hojo’s Teaching Adventures
Form ocean currents

Difficulty: Easy / Materials: Basic
Learning about oceanography? Demonstrate how ocean currents form using warm and cold water (and a few plastic sea creatures for extra fun!).
Learn more: Ocean Currents at Life Over C’s
Understand the impact of non-renewable resources

Difficulty: Easy / Materials: Medium
This is a neat Earth Day activity. Discuss the differences between renewable and non-renewable resources, then have your class form “companies” to “mine” non-renewable resources. As they compete, they’ll see how quickly the resources are used. It’s a great tie-in to energy conservation discussions.
Learn more: Non-Renewable Resources at The Owl Teacher
Explore blood components

Difficulty: Easy / Materials: Medium
Use simple kitchen supplies to create a jar full of “blood” that includes plasma, platelets, red blood cells, and white blood cells. (You can even snack on the blood cells along the way!)
Learn more: Blood Model at Almost Supermom
Create cool colors with candy
Difficulty: Easy / Materials: Medium
Learn about diffusion in the sweetest way! Grab a bag of Skittles for this quick and easy 4th grade science project.
Wow them with glowing water

Difficulty: Easy / Materials: Medium
Your students will ooh and aah at the result of this exploratory way to show phosphors in action with a black light, different types of water, and a highlighter. The results of this experiment might surprise both you and your students!
Learn more: Glowing Water Experiment at Cool Science Experiments Headquarters
Keep the STEM excitement going with these 25 Fantastic Free 4th Grade Math Games.
Plus, sign up for our newsletters to get all the latest teaching tips and ideas, straight to your inbox.


